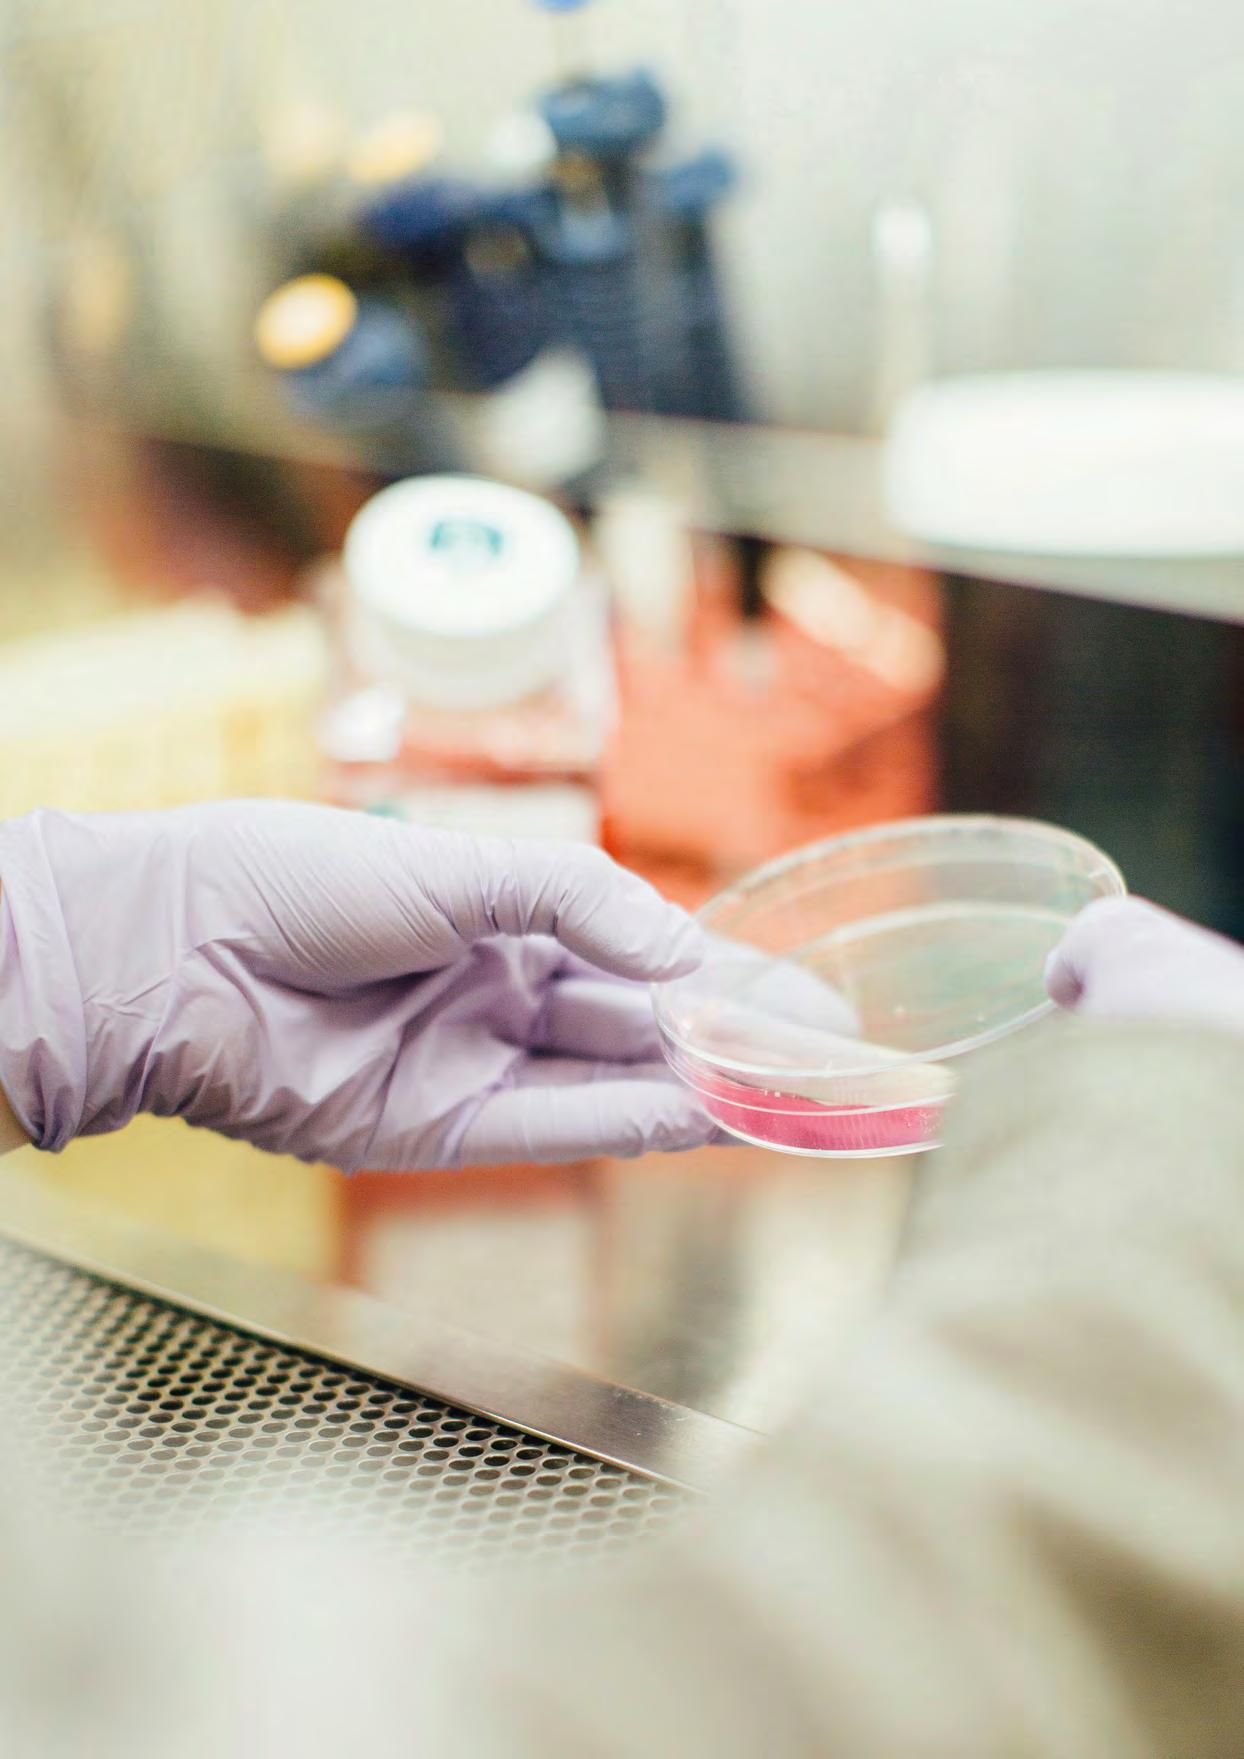

A Level Curriculum Booklet 2025





Life in the Sixth Form at Bancroft’s will provide an exciting and hugely rewarding experience that will not only prepare you for the rigours of A Levels, but also provide a transformative experience that will equip you with the life skills that will enable you to flourish whatever your chosen career path may be.
The Sixth Form is a time to develop your personal talents and interests, your scholarly approach to study, and your skills of leadership and teamwork so that you are ready to take on the challenges of life beyond school. The two years in the Sixth Form act as a bridge between the relatively ordered style of GCSE courses and the more independent and dynamic world of university, work, and life beyond the school gates.
Outline of the 16+ Curriculum
• You will start with either four A Levels or three A Levels plus an EPQ in the Lower Sixth
• Within the EPQ (Extended Project Qualification) there will be considerable scope for pupils to engage in an almost limitless range of possible research pathways - all carried out independently. You may choose to undertake a more traditional dissertation, or explore a more creative opportunity (see page 56)
• All Lower Sixth pupils will follow a life skills programme. They will be taught research skills in their first half term followed by a further selection of Individual life skills, including personal, financial, employment and wellbeing
• Comprehensive support is given to help you prepare for Higher Education and Careers
• Learning for Life will be delivered as part of the curriculum focusing on relationships and sex education (RSE). This will take place once per fortnight
• Spor ts are compulsory for all and take place on Wednesday afternoons. There are a wide variety of options available to suit all, from team sports to individual pursuits, and students are encouraged to explore as many options as they can. We place great value on the opportunity to step away from the classroom and dedicate time to exercise and personal wellbeing
Participation in the wide range of societies, sports and activities beyond the classroom, both within the house structure and outside it, is an essential part of being a Bancroftian. These areas will enrich your Sixth Form experience immensely; they will help you to enjoy life and support your academic studies; and they will also help you to develop vital skills: in leadership and team-work; in organisation and responsibility; and in resilience and adaptability, all of which are highly valued in later life. We hope that anyone joining the Sixth Form at Bancroft’s School will look for the opportunity to learn new skills and contribute to the school community, ensuring their time in Bancroft’s Sixth Form is well spent and of value to the rest of their lives. The aim for each student is to leave Bancroft’s fully prepared, not only for the continuation of their personal journey, but also as mature, confident, responsible, and well-grounded members of society ready to make a positive impact in the community and beyond.

Mr Harrison Head of Sixth Form

of the
“Sixth Form has done a great job in preparing me for life beyond school.”
Upper Sixth Leaver
Every Sixth Former is a member of a house led by a Housemaster or Housemistress who will support each pupil throughout their time in the Sixth Form. The Housemaster/ mistress is closely involved in helping students to make important decisions regarding further education and career choices. Within each house, students are grouped into tutor groups led by House Tutors. Tutor groups are small, enabling the Tutor to offer day-to-day support to individuals.
Members of the Sixth Form are encouraged to become involved in some of the many and varied house and school activities. From Easter of the Lower Sixth, all students are invited to become monitors and take on responsibilities as senior members of the school. Some may also apply to become House Prefects, assisting a Tutor with one of the junior tutor groups.
The Lower and Upper Sixth have a shared common room with a café, and a Sixth Form Library for quiet study. Mrs Brough and Mrs Dean are based in the Sixth Form library and are on hand to provide guidance and advice on university applications and careers, innovation, and entrepreneurship. Student Congress looks after the day-today management of the Sixth Form common room, under the guidance of the Head of Sixth Form.
Bancroft’s offers Sixth Formers the chance to enjoy a wide range of activities, offering many opportunities and challenges for personal development and leadership.
All Sixth Formers take part in a games on Wednesday afternoons. Students who are selected to represent the school in a major sport will be required to train or compete in that sport on a Wednesday, as follows:
Autumn TermSpring Term Summer Term
One of the key events in the school year is the House Drama Festival, which occurs in the Autumn Term. Each house produces its own play with students taking on responsibility for all aspects of the production, including writing the script in many cases. The senior school play is staged in the Spring Term, and this major production offers considerable opportunities in all aspects of drama. The Performing Arts Centre supports excellence in drama both in and out of the curriculum – whether run by students or staff.
The school choir and orchestra rehearse weekly and prepare for a range of concerts. A chamber choir - the Bancroft’s Singers - has an ambitious programme, performing at a variety of venues both in and out of school. A great variety of other musical ensembles meet to make music in many contexts, and are often led by Sixth Formers. Instrumental teachers cover the whole musical range and private lessons can be arranged for Sixth Formers to fit in with their academic timetables.
Bancroft's offers a number of adventurous and outward bound activities, each of which attract roughly equal numbers of male and female participants. There is a large Combined Cadet Force and a Duke of Edinburgh's Award Scheme group, which sees a significant number of students completing the Gold Award during their time at Bancroft’s. Those new to the school are encouraged to join these groups, and build on any qualifications or experience they may have acquired elsewhere. There are also a range of curriculum trips and sports tours available across the year.
Students can choose to participate in a range of other activities as well, from academic based societies - such as the Physics or Modern Foreign Languages Societies, to setting up and running their own society for pupils in the lower school.
There will also be the opportunity of running for one of the senior positions in the School Congress and ultimately, a position of responsibility within their respective Houses in Upper Sixth. This is to say nothing of the wealth of opportunity within sport at Bancroft’s, including rugby, hockey, netball, cricket and football to name but a few.
Boys Rugby/FootballHockey/FootballCricket
Girls HockeyNetballTennis
For other Sixth Formers there is a large range of activities available including aerobics, athletics, mountain-biking, badminton, climbing, fitness training/ crossfit, football, golf, lifesaving, rifle shooting, rounders, self-defence, squash, swimming, table tennis and trampolining. Students are encouraged to make full use of all the excellent facilities available in and around the Sports Hall including the playing fields, courts, a 25m heated indoor pool, fitness suite, and a new crossfit centre at the West Grove playing fields – and enjoy the benefits of being active and healthy.

Over the last fifteen years, Bancroft’s has consistently sent almost all of our Upper Sixth pupils to the leading universities in the UK and North America, including Oxbridge and Russell Group Universities. An increasing number of students have gained places on highly competitive degree apprenticeship programmes with the likes of Dyson, PWC, and JP Morgan.
Others choose to enter directly into employment or take a gap year that usually involves some charitable/volunteering work overseas. The post-18 options are increasing every year and Mrs Dean in the Careers Office can provide extensive and detailed guidance on all available options.
Most Upper Sixth pupils will sit exams in three A Level subjects. Around a third of the year, for example those who are taking Further Maths, may sit four subjects in total. For many, their formal academic curriculum will be enriched by undertaking the Extended Project Qualification (EPQ – see page 56) that will run alongside their other three A Levels. The EPQ is increasingly being valued by institutions and may form part of a revised or adjusted offer if pupils achieve an A or A* for this. Another option for pupils is for them to supplement their three full A levels with an AS course in a language – this could be a modern language, such as French or Spanish, or a classical language, such as Latin.
Universities will typically use a combination of the following criteria when making offers (in no particular order):
• GCSE results and your academic trajectory
• UC AS Predicted grades – based partly on your performance in the Lower Sixth exams (internal) and your teachers’ professional judgement
• School reference written by your Housemaster/ mistress and subject teachers
• Personal Statement
• Performance in any admission test, if applicable
Competition for the leading universities is growing. As a result, they will expect to see a good set of GCSE grades (7, 8, and 9s) and a clear upward trajectory throughout the Lower Sixth year. It is therefore vital to work hard through this year as any UCAS grades will based on your approach to work across the year and not exclusively on any exam performance.
As a result of increasing competition, offers for leading universities usually require a minimum of AAB or higher in A Level exams; for more competitive institutions/courses, this will also involve achieving at least one A*. Typically for example:
Cambridge: Two A*’s for STEM subjects; one A* for arts/ humanities
Oxford: Two A*’s for Maths and one A* for the majority of other courses
Imperial: Often demands two A*’s for STEM related subjects
Warwick, Bristol, Durham, Birmingham, LSE, UCL, Edinburgh: Usually require at least one A* for more popular/ competitive courses.
A* predictions are not given without merit. For pupils wanting an A* grade in any subject, they must demonstrate a combination of academic ability, diligence when working independently (free periods), and increasing ownership and independence when planning for progress (self-reflection).
Pupils should bear this in mind when selecting their A Level subjects; the subjects they choose must be ones they most enjoy and are intellectually curious about – this will make
the process of learning exciting and enjoyable, which is the key to success. The most competitive universities/courses are increasingly using interviews and other assessments as part of the selection process, so genuine enthusiasm for your studies is essential. Pupils need to think carefully about their A Level choices as, to a certain extent, the choice of degree can be defined by the A Levels they study. This is certainly the case for courses such as (but not exclusively) Medicine (Chemistry and Biology), Engineering (Maths/ Further Maths and Physics (if applicable) and Economics (Maths/Further Maths).
There are, however, many misconceptions about A Level choices and the possible impact on degree courses and future careers. In many cases jobs are non-subject specific; employers commonly use a degree merely as a measure of academic ability. Success in obtaining places on such courses, as well as other employment opportunities, is often as much about the personal skills and attributes an individual possesses. Therefore, unless pupils have a clear idea about what course/career they want to go into, we would encourage all pupils to consider a well-balanced A Level subject diet, choosing subjects that they enjoy, are good at, and offer a broad range of skills (e.g. a balance between STEM, social sciences (arts/humanities) and languages).
The Higher Education & Careers programme is coordinated by the Sixth Form leadership team; Mr Philip Harrison (Head of Sixth Form), Mrs Michelle Dean (Head of Careers), Miss Laura Mason (Head of Lower Sixth), Mrs Nisha Patel (Head of Upper Sixth) and the Higher Education Team; Mr Justin Choy (Head of Medics) and Dr Stuart Hunn (Oxbridge coordinator). The programme begins for the Lower Sixth in the second half of the Autumn term and is generally completed by the October half term of the Upper Sixth. There is a wealth of expertise on the teaching staff; subject teachers, tutors, and Housemasters/mistresses are available to ensure that students have the opportunity to make informed and realistic decisions about their future. Additional insight is provided by: guest speakers from university admissions teams, Old Bancroftians currently at university, parents with experience in specific careers/industries, and a careers and higher education fair. Interview training, both general and academic is also provided. Candidates applying to Oxford, Cambridge, or for Medicine and other competitive courses that rely on interview for an offer will receive additional assistance. For example, practice interviews with external academics or current medical professionals are arranged. Such students are expected to be rigorous in their preparation and attend additional classes.
Students at Bancroft’s will have access to the latest resources on which to base their research, which are either available in the 6th form area or on the web. In the Lower Sixth, Medics
groups meet once a fortnight in the place of a free study period in order that more can be found out about these careers and how to apply for related courses at university.
Bancroft’s also provides guidance for students applying to US universities. These institutions offer a liberal arts education which provides students with flexible learning opportunities, including interdisciplinary learning, a focus on team-based work and an emphasis on a broad skill set in both the arts and sciences. Typically, degree courses are better for generalists, since students do not pick their major until the third year (of a four year course). If this is something pupils are considering, it is worth bearing in mind when selecting A Level subjects. The US universities also have well developed careers departments with a history of work experience and internship partnerships with industries of all kinds. These experiences could be invaluable in today’s rapidly changing employment market.
As competition for university places increases every year the number of qualified graduates hitting the job market is also on the rise. As a result, many companies and corporations are offering employment opportunities straight from school, some with the opportunity of completing a degree at a later stage, after initial training. Many of the big firms such as PWC and KPMG offer degree apprenticeships, in areas such as accountancy and finance. Successful applicants would essentially be employed but spend a number of months studying at university (such as Nottingham or Durham) with the remainder of the time working and completing their training. This can be an interesting route into the world of work whilst at the same time obtaining a degree. Benefits obviously include a guaranteed job (upon training completion), a university degree and a healthy starting salary, negating the problem of student debt incurred during a traditional degree program. They tend not to be subject specific and grade entry requirements tend to - but not exclusively - be lower than the UK’s leading universities.
“Not only does Bancroft’s push you to be the best version of yourself academically, but also helps to shape you as an all-rounder.”
Upper Sixth Leaver 2024

Choosing your combination of A Level subjects is an important decision and you will need to consider a number of factors. First and foremost you should opt for the subjects that you will enjoy the most and have a passion for beyond the classroom. A significant portion of Sixth Form education involves independent study; enjoyment of a subject will therefore foster motivation, one of the most critical elements of successful, independent study. However, you will also need to take into account the entry requirements for any university courses you have in mind. Ideally you should achieve grade 8/9 in subjects related to your chosen A Levels to have a solid foundation for further academic progress. In order to study a subject where core mathematical competencies are necessary, such as Economics or Physics, it is expected that a grade 7 in GCSE Mathematics is achieved.
You will find a distinctly different atmosphere in the Sixth Form. As with every stage of education at Bancroft’s, your teachers will guide your studies and insist on high standards.’ However, the lessons represent only 50% of the time you will need to spend studying each subject in order to master the material and develop the required skills. The Sixth Form is about developing excellent independent work habits and time management skills. There will be considerable opportunities to use time in school for private study; it is this that is often decisive in achieving examination success and preparing for life beyond school.
As already noted, students have the option to choose four subjects or three and an EPQ or an AS is a language. As those on four continue on to the Upper Sixth year they may either continue all four through to their conclusion or choose to drop one.
In making decisions about choices, the following points may be helpful:
• You should study subjects which you enjoy and wish to study further;
• You should consider studying subjects in which you are likely to achieve your best grades;
• You may wish to consider new subjects which do not require you to have studied them at GCSE (marked * in the index on page 13);
• It is impor tant that the A Level subjects chosen have some pattern to them and while straightforward preference is a significant factor, you should also consider the entry requirements for any university courses or careers that you have in mind (see page 8);
• The ability to choose four subjects in the Lower Sixth is an opportunity to broaden your choices, and you should consider whether it is right for you to take a fourth subject which complements or contrasts with your other three.

Completing an EPQ allows pupils to develop the independent research skills and study habits that universities are commonly looking for. As such, they are very highly regarded.
Although you will be responsible for your final selection of subjects, you should consider the expert advice offered by your teachers, your Housemaster or Housemistress, the careers staff and others.
We allow students a free choice of subjects and do not run pre-decided option blocks to choose from. We then design the timetable around these choices. There is sometimes a very small number of students who make choice combinations which do not fit with the rest on the timetable, in which case we will be in contact and give appropriate advice. Similarly, if a very small number of students pick a particular subject, it may be the case that we decide we cannot run it, in which case we will be in contact.
Double Maths is counted as two subjects in terms of options and leads to two A Levels – Maths and Further Maths. See page 42 for more details.
At Bancroft’s we encourage the safe and responsible use of electronic equipment. Whilst phones may at times be used, with the teacher’s permission, they are not suitable for indepth class study and students must adhere to the school’s mobile phone policy. We therefore require Sixth Form students to have a suitable device to support their learning. These are widely made use of during lesson time and pupils are also free to use them in the Sixth Form Common Room, Library and Seminar Room. Further details about devices and specifications will be made available to pupils and parents in due course. To ensure safe and responsible use of electronic devices all students are expected to view and agree to the school’s E-charter.
If you have a particular career or course in mind it is important that you research carefully what qualifications are required. Details of most courses in universities and colleges of higher and further education are available in the Sixth Form Library. The Heads of Department and teachers of relevant subjects will also be happy to help and advise.
Archaeology
No specific A Level requirements
The table below gives guidance on the A Level subjects necessary or often preferred for a range of degree choices. It is based on the Russell Group of 20 universities to which the majority of students from Bancroft’s will go. The table is not meant to replace the advice above; institutions differ in their entry requirements even within the Russell Group, so individual research is still recommended. A good place to start is the “Informed Choices” website. Visit the site via: www.informedchoices.ac.uk
Architecture Art usually required & portfolio; Maths preferred; Physics sometimes preferred
Art Foundation Art necessary & portfolio
Biochemistry
Biological Sciences
Chemistry required; Biology usually preferred;
Chemistry required; Biology preferred; Maths sometimes preferred
Biology Biology required; Chemistry usually required
Business / Management Maths often preferred
Chemistry Chemistry required and another science, often Biology; Maths often preferred
Classical Studies Neither Latin nor Greek required
Classics Latin or Greek nearly always required
Dentistry Chemistry and Biology nearly always required
Economics Maths preferred some prefer Further Maths; Economics not always necessary
Engineering Maths & Physics required; some prefer Further Maths
English
Modern Languages
Geography
English required
French required for a French degree; German and Spanish almost always required for a degree in those languages; all others can be ab initio (& combined) but a language to A Level is required
Geography usually required
History History usually required
Law No specific A Level requirements; breadth often welcomed; English sometimes preferred
Mathematics Mathematics required; Further Maths preferred
Medicine Chemistry required; Biology usually required; a third Science (Maths or Physics) sometimes preferred
Pharmacy
Chemistry required and usually another science
Physics Physics and Maths required; some prefer Further Maths
Psychology A Science often required; Maths sometimes preferred
Sports Science A Science usually required; PE sometimes preferred
Theology / Philosophy No specific A Level requirements
Veterinary Medicine Biology, Chemistry required; a third Science (Maths or Physics) sometimes preferred
The following subjects are offered; details are available on the pages indicated:

* indicates a subject may be taken without having been studied at GCSE level

If you enjoy being creative, want to improve your practical application and enhance your analytical, communication and research abilities, then Art and Design is the right choice for you. The wide range of skills you stand to gain will not only complement other subjects but are qualities you can draw upon in life outside of school. Students without a GCSE in Art and Design have been admitted onto the course in the past and have been very successful.
At Bancroft School, we believe that studying Art and Design can be a life-changing experience. By pursuing this subject, you will develop your creativity, analytical skills, and communication abilities, which will benefit you not only in your academic journey but also in your future career.
Our Art and Design course is designed to give you the freedom to explore your own creative interests, work independently, and collaborate with others. You will have the opportunity to develop a range of skills, including drawing, printmaking, photography, animation, and film making. Our course is unique in that it allows you to set your own agenda and focus on topics that are personally relevant to you.
Art students are highly sought after by employers because they develop a range of skills that are valuable in many industries. Employers recognize that art students are creative problem-solvers who can think critically and communicate effectively. In fact, many successful companies, including Apple and Google, actively seek out students with a creative background to join their teams.


The course is divided into two units:
Unit 1: Personal Investigation (60% of A Level)
• Submit a practical portfolio of work based on a starting point of your choice
• Complete a related written study of 1000-3000 words
Unit 2: Externally set assignment (40% of A Level)
• Respond to a specific theme provided by OCR
• Produce preparatory studies based on the topic, then produce an outcome within 15 hours of controlled time
Assessment
• All work is internally marked and externally moderated
• Four equally weighted assessment objectives cover recording and exploring, analysing and evaluating, investigating and developing, and realising intentions
We offer a range of extracurricular activities to support your studies, including gallery visits, museum visits, and workshops on topics such as animation and printmaking. We also invite guest speakers from the art world to share their experiences and insights with you.
• Record experiences and observations using drawing or other visual forms
• Explore relevant resources, analyse, discuss, and evaluate images, objects, and artefacts
• Use knowledge and understanding to develop and extend thinking
• Generate and explore potential lines of enquiry using appropriate media and techniques
• Organise, select, and communicate ideas in a range of visual, tactile, or sensory forms
• Those who have chosen to continue their education in Art have gone on to study Architecture, Fine Art, Animation, Design, and Textiles at University and Art College
• Many pupils have successfully entered into careers in medicine, dentistry, veterinary science, law, engineering, and more
• Launch successful careers in advertising, media, marketing, gallery curation, architecture, video game design
University and Beyond
For those who choose to continue their education in Art and Design, we have a strong track record of success at University and Art College. Many of our former students have gone on to study Architecture, Fine Art, Animation, Design, and Textiles at top institutions. We proudly follow and encourage all of our pupils’ achievements and maintain close links with many of our Old Bancroftians.

The primary aims of the course are to promote an interest in and enjoyment of the study of living organisms, to develop an understanding of Biology and to appreciate its significance to ourselves and to the world in which we live. This is achieved by focusing on aspects of the subject that are relevant to our everyday lives and possible career requirements.
Exam Board: AQA
Why should I study Biology?
You should study Biology primarily because you find it interesting and would like to find out more about the fascinating world of the living organism. It is a rewarding challenge for students who are scientifically competent, and it provides the opportunity to develop many skills such as problem solving and research.
What will I study?
The specification covers all aspects of Biology from molecules and cells through biological systems to genetics, evolution, biotechnology and ecology. In all cases the applied aspects of Biology are emphasised but the teaching also ensures that a thorough understanding of the basic principles is achieved.
How will I be assessed?
We study AQA Biology which is assessed by three 2-hour written papers, largely a mixture of short and long answer questions, with one essay in the third paper. There will also be 12 compulsory practicals which will be marked over the 2 years. One of the practicals will be carried out on the field trip to Norfolk in June of the Lower Sixth.
How else will my studies be supported?
There is the opportunity to spark and further your enthusiasm for Biology in a fortnightly discussion club, which gives the chance to discuss articles or books you’ve recently read, get involved in dissection/suturing society and opportunities to compete in national competitions. In addition, there have been trips available, the main one being the compulsory residential field trip to Norfolk at the end of the Lower Sixth. The field trip will involve both coastal and terrestrial ecology, studies being made of the interaction between plant and animal communities and their physical environment and of the effect that man can have on the environment.
Skills gained
Biology helps you to build up research, problem solving, organisational, and analytical thinking skills. You will also acquire the ability to apply factual knowledge to new situations and develop your practical skills.
University and beyond
Biology is a key subject for lots of STEM careers, particularly in healthcare, medicine and jobs involving plants or animals. Possible careers include: nursing, dentistry, forensic science, psychology, physiotherapy, botany, environmental science, zoology, geology, oceanography, pharmaceuticals, energy, teaching, science writing, genetics and research. Biology is also excellent preparation for nonscientific careers, thanks to the skills it provides, everything from analytical thinking to writing reports.

The course aims to provide pupils with an understanding of the nature and problems of business through an investigation of the decision-making processes and environment within which business operates. The perspectives of all stakeholders are considered.
There are no formal entry requirements other than a genuine desire to learn how businesses are organised, operate, plan and make decisions. Skills developed during the course include communication, application of number, problem solving and working with others.

The A Level Business course introduces students to some of the key issues and concerns. Are you are interested in questions such as How is Brexit still affecting businesses? What will be the implications of current cost of living? How and what do businesses decide to produce? Why are some businesses more successful than others? How will current changes in interest rates affect investment decisions?
The examination is based on real businesses, and so during the course of the two years you will need an interest in current affairs – What businesses are in the news and why? What are the forecasts for the economy and how will it impact on business decisions?
Business will give you a greater understanding of the business environment whilst developing key skills required to analyse and evaluate business behaviour.
It should be noted that Economics may not be taken alongside Business as there is too great an overlap in the courses.
What will I study?
The course comprises of four Themes. Themes 1 and 2 are studied in Year 1. Themes 3 and 4 are studied in Year 2.
Theme 1:
Marketing and People
Students will develop an understanding of:
• Meeting customer needs
• The market
• Marketing mix and strategy
• Managing people
• Entrepreneurs and leaders
Theme 3: Business decisions and strategy
Students will develop an understanding of:
• Business objectives and strategy
• Business growth
• Decision-making techniques
• Influences on business decisions
• Assessing competitiveness
• Managing change
Theme 2: Managing business activities
Students will develop an understanding of:
• Raising finance
• Financial planning
• Managing finance
• Resource management
• External influences
Theme 4: Global business
Students will develop an understanding of:
• Globalisation
• Global markets and business expansion
• Global marketing
• Global industries and companies
The course involves a certain amount of number work, but it is basic numeracy rather than mathematical ability which is required, and more than half the marks in the examinations are for qualitative judgments rather than “number-crunching”.
How will I be assessed?
The course is assessed over three Papers each of which is two hours long.
• Paper 1: Marketing, people and global businessassesses the content covered in themes 1 and 4.
• Paper 2: Business activities, decisions and strategyassesses the content covered in themes 2 and 3.
• Paper 3: Investigating business in a competitive environment – this is a synoptic paper drawing on students’ knowledge of all areas of the syllabus.
All of the questions are data response based on case studies of real businesses.
How else will my studies be supported?
In order to provide context to the theory being studied students will visit businesses and where possible, speakers from local businesses are invited in. Regular support sessions are also offered to help students consolidate their understanding of areas which are of particular concern to them.
The course will enable students to gain a range of transferable skills including:
• Cognitive skills such as non-routine problem solving; decision making and reasoning; critical and ICT literacy
• Interpersonal skills such as communication; relationshipbuilding skills and collaborative problem solving
• Intrapersonal skills such as adaptability, self-management and self-development
University and beyond
Students can progress from this qualification to:
• Higher education courses such as business management, business administration, accountancy and finance, human resource management, marketing, retail management, tourism management and international business
• A wide range of careers ranging from banking, sales, product management, general management to working in public sector organisations or charities.
The A Level Chemistry course at Bancroft’s aims to and develop a candidate’s knowledge and understanding of Chemistry, and foster analytical skills. It also hopefully enhances a candidate’s enthusiasm for Chemistry and Science in general. Pupils who have enjoyed all aspects of the GCSE Chemistry and who like mathematical and conceptual challenges would find this course attractive.
It is open to students who have studied GCSE Chemistry or Trilogy (double award) Science courses.
Exam Board: AQA
Why should I study Chemistry?
Chemistry is a vibrant and exciting subject. It is involved in everything around us - from the making of new materials to understanding biological systems, from the fuels we use to the medicines which keep us healthy, and from the fabrics we wear to keeping the air we breathe healthy. It is often called the central science and has overlap with Biology, Geography and Physics.
The course splits chemistry into three components.
1. Physical Chemistry is the study of the main principles of chemistry. It incorporates the mole, energy, structure and bonding, equilibrium, rates of reaction, acids and bases. Many of these topics become more mathematical as the course proceeds.
2. Inorganic Chemistry is the study of the elements in the periodic table and their compounds. It includes a study of Groups 2 and 7, and the transition metals.
3. Organic Chemistry. This is the study of carbon-based chemistry from simple alkanes through to polymers, medicines and the molecules of life.
How will I be assessed?
At the end of the Upper Sixth, all components of this course will be assessed in three, 2-hour examinations. Practical work is completed throughout the course. There are required practicals that must be recorded in a laboratory book as evidence for the practical competency component of the A Level. The knowledge and understanding gained from the practical activities will be examined in the final written examinations.
There is no coursework component to the A Level Chemistry.
How else will my studies be supported?
We have extensive online resources to support your study written by teachers at Bancrofts. The Chemistry Department offers Sixth Form extension classes where we look at concepts outside of the A Level and prepare for competitions like the International Chemistry Olympiad. You also have the opportunity to participate in chemical research as part of our ionic liquids project.
Skills gained
There are a range of skills that will be developed by studying A Level chemistry. You will develop analytical thinking skills and the ability to apply concepts to new situations. A successful chemist needs to be able to link the abstract, microscopic world of the atom and electron to the macroscopic observations of experimental work. Understanding the concepts is as important as the reproduction of factual material. You will develop your mathematical skills which are required to cope with the quantitative aspects of the course. You will also develop your practical skills. Experimental work is an important part of the course with many of the theoretical discussions based upon results from it.
University and beyond
Chemistry is obviously essential for degrees in chemistry and most Natural Science degrees. Chemistry has a significant part to play in the understanding of applied fields of medicine, chemical engineering, geology, food science and materials science. It is an essential entry requirement for many scientific and medicine based degrees and a useful A Level for many more.
Classical Civilisation can be taken up by those who have not studied Classical Civilisation (or Latin or Greek) at GCSE. Over the two years, three distinct components are studied; they are important and interesting in themselves and have significance for the development of Western Civilisation.
Exam board: OCR
Why should I study Classical Civilisation?
• You will have the opportunity to read and enjoy some of the earliest surviving, and most highly-regarded, works in the Western literary canon.
• You will evaluate the culture of ancient Greece and Rome, using this fresh perspective to reflect on your own experiences and perspective.
• You will develop insights into the relevance of ancient literature and civilisation to our understanding of our modern world of diverse cultures.
• You will combine the source analysis of History, the literary criticism of English and the cultural comparisons of Religious Studies.
• You will be introduced to elements of Archaeology and Anthropology.
• You will learn how to appreciate and respond to a wide range of sources.
• Because the material is so wide-ranging, interesting and engaging, you will find it fascinating and enjoyable!
will I study?

The three components are:
• The World of the Hero. This is a compulsory component consisting of an in-depth study, in translation, of the epics of Homer (Odyssey) and Virgil (Aeneid).
Key topics for both epics are:
Literary techniques and composition; the heroic world: characterisation and themes; the social, cultural and religious context.
His torical and political background is an additional key topic for the Aeneid.
• Culture and the Arts: Greek Theatre. This component involves the study of prescribed visual and material culture (e.g. archaeological evidence and artefacts), combined with the study of Sophocles’ Oedipus the King, Euripides’ Bacchae and Aristophanes’ Frogs – all in translation.
Key topics are:
Drama and the theatre in ancient Athenian society; nature of tragedy; nature of (old) comedy; literary techniques, structure, and dramatic conventions; social, political and religious themes in tragedy and in comedy.
• Beliefs and ideas: Love and Relationships. This component involves the study of an area of Classical thought, in combination with literature in translation. The works of Plato, Seneca, Sappho and Ovid provide the source material; the interpretation of this evidence is an integral part of the course.
Key topics are:
Men and women; Plato and Seneca on love and desire; love and relationships in Sappho and Ovid; ethics and values relating to love, desire and relationships.
How will I be assessed?
Each written examination tests AO (Assessment Objective)1 [demonstrate knowledge and understanding of literature, visual/ material culture and classical thought] and AO2 [critically analyse, interpret and evaluate literature, visual/material culture, and classical thought]. Paper NameMarksTime
The World of the Hero
1002 hours 30 minutes 40
Greek Theatre
751 hour 45 minutes 30
Love and Relationships
751 hour 45 minutes 30
How else will my studies be supported?
You will have the opportunity to attend drama productions and visit museums. You may have the opportunity to acquire a deeper understanding of the topics studied and the Classical World in general by attending lectures and conferences on a variety of topics. You will have the opportunity to attend Classical Society (which holds regular meetings, covering a wide-range of topics) and to research a subject of your choice to enable you to deliver a talk. You will have the opportunity to assist in the running of Junior Classics Club and to enter essay competitions. You may have the opportunity to participate in a school visit to either Greece or Italy.
Skills gained:
You will learn how to assess, compare and contrast cultures different from those of the modern world and to make connections and comparisons between aspects of Greek and Roman society and your own. You will develop skills in interpreting, analysing and evaluating a wide range of evidence. You will learn how to form your own judgements,
• 10-mark stimulus
• 20-mark essay
• 30-mark essay (requires some analysis and evaluation of the opinions of modern scholars
• Short answer
• 10-mark stimulus
• 20-mark essay
• 30-mark essay (as above)
• Short answer
• 10-mark stimulus
• 10-mark ideas
• 20-mark essay
• 30-mark essay (as above)
how to contribute to discussion and how to listen to, analyse and evaluate the views of others. You will learn how to articulate a clear, concise and informed response to the material studied, using a range of appropriate evidence to formulate coherent and substantiated arguments. You will develop an awareness of how the Classical sources reflect issues relevant to both the Classical World and today, such as questions of gender, belief, sexuality and citizenship.
University and beyond:
Classical Civilisation may be studied further as a highlyregarded Honours course (some, but by no means all, courses include modules which require study of Latin and/ or Greek ab initio) or as part of a Joint Honours course. The intellectual qualities which will be developed by a Classical Civilisation graduate are in great demand in a wide range of careers; employers especially value the diverse skillset which Classical Civilisation graduates have built up during their studies. Those who continue to study Classical Civilisation at university often proceed to careers in journalism, the media, politics, industry, or the computing world.
Computer Science is the study of Computers, how they work and how to develop them in order to best solve human needs. In contrast to ICT, in which students would be expected to just use computers, Computer Science aims to give a fuller understanding of how we can make our own software in order to make bespoke solutions to a variety of areas.
This course is a direct continuation of the Computer Science GCSE and it is therefore recommended that the GCSE has been undertaken to apply for this course. Students will study all aspects of how a computer functions on a day to day basis. This includes: advanced data structures and for the visualisation of complex problems; the protocols and algorithms involved in communication between computers; and how CPU’s process data in both a sequential and parallel fashion to increase system performance. Furthermore, students will take on the study of algorithm design. This area is highly recommended in order to develop future problem solving skills. This will include learning to programme using the Python programming language, as well as design algorithms in a variety of ways including flow charts and pseudocode. Many of these abstract techniques are used in other areas of business in the modern world.
This course will take you to the next level of Computer Science. By the end of this course you will be ready to take on complete programming products yourself, complete with graphical user interfaces. Furthermore, those looking to complete a career with any software development elements will emerge from the course with the start of a professional portfolio of work to share with employers. This is still commonly done and is brilliant evidence of your ability to code.
For those looking to start their own business; you will have enough Computer Science skills by the end of this course to have a strong grasp of production code to create your own systems. You just need to be creative. Computer Science is also very logic based, which delivers excellent analytical and critical thinking skills that can be used in many areas of work, outside of technical fields.

Computers will be a big part of everyone’s future. There are an overwhelming number of careers presenting themselves within the working world. Starting a career within Computer Science would open up opportunities in a large number of industries including: Application Development, Banking, Education, etc.
There are a wide variety of topics you will study. Below is a full list of the topics covered within the A Level
• Struc ture and Function of the processor
• Type of Processor
• Systems Architecture
• Application Generation
• Software Development
• Types of Programming Languages
• Compression and Encryption
• Databases
• Networks
• Web Technologies
• Advanced Data Types
• Data Structures
• Boolean Algebra
• Moral and Ethical Issues
• Comput ational Methods
• Thinking Concurrently
• GUI Design
How will I be assessed?
The A Level is comprised of two external exams and an internally assessed non-examinable assessment. The weightings of the assessments are as follows:
How else will my studies be supported?
Students will have the opportunity to take part in a wide range of activities outside of lessons to support their development within the Computer Science discipline. These include leading of your own clubs to gain leadership experience and to instill coding skills.
Skills Gained?
• Problem solving
• Modular design
• Collaborative working
• Tech leadership
• Understanding of emerging technologies
• Computer programming and design
• Robust systems testing
• Awareness of computer systems for business


Why should I study Design and Technology?
Design and Technology is fundamental to our modern economy and key to driving change and innovation. It is an inspiring, rigorous, and practical subject that provides those who take the course with the creative energy and proactive skills to positively shape the world we live in for the benefit of all.
This highly respected qualification opens the door to a wide range of careers in the creative, engineering and manufacturing industries as well as being excellent preparation for numerous other professions. Design and Technology is purposeful, as well as being fun and exciting! People with Engineering and Technology degrees earn approximately 20% more per year than the average graduate salary. The course appeals to those who have an enquiring mind, a desire to solve problems and a sense of how the modern world deals with changing trends and demands.
What will I need to study the subject?
We welcome students who have studied Design & Technology and/or Engineering or related subjects at GCSE but also those who wish to pursue the many exciting career opportunities and pathways on offer. Students should (ideally) have gained a grade 7 in their D&T GCSE course with a 7 in Maths. Where students have not followed a GCSE in a Design & Technology subject, they will be assessed upon an individual basis to decide upon their suitability to study the course. It is recommended that students taking the Design & Technology course should also take A Level Maths alongside the subject as Engineering at Further and Higher education level requires and includes a high-level understanding of Mathematics.
The syllabus we follow is the OCR Design and Technology Product Design course (H406) which is seen as academically rigorous by university admissions tutors, and employers. Many Engineering courses at university like Design and Technology as the third A Level choice, and the skills and knowledge you gain from the course would also prepare you for apprenticeships, and the workplace.
The first year of the course is divided into separate modules, commencing with an induction course. Students
studying the Design & Technology course will undertake a broad approach to engineering through the iterative design of products and gain skills to communicate visually through coursework projects and theoretical knowledge. Design & Technology coursework is focused on mechanical engineering, mechatronics and electronic products and systems. Analysis of products in respect of function, operation, components, and materials is used to understand their application and uses with a view of commercial viability.
Design sketching forms a part of the course as does using mathematics and science to underpin technical considerations. The use of industry standard CAD software is included in the course, alongside more traditional skills such as rendering, marker pen work and presentation. 3D modelling is integrated with 2D graphic techniques to produce students with outstanding skills. Integral to the course is the iterative design process. Students are encouraged to become independent learners and will gain an understanding of and simulate the work of professional engineers/designers in their project work.
A focus on implementing the skills learnt in the first year will lead to high quality coursework outcomes. A folder of work will lead to a quality prototype model and work suitable for portfolios.

as a range of enrichment opportunities. This includes educational visits, such as day trips to New Designers, the Design Museum, and industry-based visits. There is also the opportunity for students to attend a subject specific residential trip which we run bi-annually to Tokyo. On top of this we invite STEM ambassadors and Engineering professionals with ‘real world’ experience into the Department to speak to students about their roles. Students are encouraged to enter national competitions with their work such as the Triumph Design Awards and the GSK Young Engineer of the Year. We also expect our students to participate in the wide range of co-curricular activities we run including the Sandy Gunn Aerospace Engineering program, VEX Robotics, Green Power Electric Car challenge, Airgineers, Bamboo Bicycle club and Bancroft’s Biplane society.
The Design and Technology course is compatible with most other Linear A Level courses, depending on your chosen career path. They include Art & Design, Business Studies, Mathematics and Physics. The exact combination for a student’s University/career choice can be discussed with staff at enrolment events. On successful completion of the course, and depending on other A Level subjects taken, students can develop their studies through a range of Higher Education courses. These include Engineering, 2D and 3D degree courses, Architecture, Product Design, Automotive Design, Aerospace Engineering and CAD/CAM based manufacturing courses to name but a few areas. It would also be valuable for students aiming to pursue career paths in Engineering professions through work-based apprenticeships.

Drama and Theatre Studies should appeal to anyone with a love of theatre. The course provides the opportunity to study plays in depth from the points of view of directors, designers, actors and critics. The A Level is a discrete subject meaning that students who have not taken Drama at GCSE will not be significantly disadvantaged, although they will need to demonstrate their abilities as an actor/ designer before acceptance onto the course.
Exam Board: Pearson
Why should I study Drama and Theatre Studies?
Drama and Theatre Studies is a balance between the academic and the creative, exploring theatre making from a range of different angles. Students gain independence in the creation of their practical pieces, as well as in the outline of their directorial and design visions for the plays they study in class. Students enjoy frequent trips to the theatre which develops their understanding of a range of contexts, eras and theatrical styles.
What will I study?
• Devising (devising practical exam and written portfolio)
• Text in Performance (scripted practical exam)
• Theatre Makers in Practice (written exam)
You will perform a devised piece, marked by your teachers, in Lower Sixth, and write a portfolio documenting your process alongside it. You will perform two scripted pieces to a visiting examiner, and you will take a written exam at the end of Upper Sixth, which will require you to write a live theatre review, to interpret a script from the point of view of the performer and the designer, and to interpret a different script from the point of view of the director.
How will I be assessed?
• Devising: 40%
Performance of original devised piece in the style of a practitioner: 10%
Written portfolio (3000 words): 30%
• Text in Performance: 20%
Group performance (3-6 performers) of an extract from a published play: 12%
Monologue or duologue of an extract from a published play: 8%
• Theatre Makers in Practice (2 hour 30 minute written exam): 40%

Live Theatre Review: 10%
Interpretation of Machinal by Sophie Treadwell as a performer, and as a designer: 18%
Interpretation of performance text as a director: 12%
How else will my studies be supported?
Throughout the course you will be taken to a large number of plays which inform both your written and practical work. You will have the opportunity to perform plays in school. You will get the chance to take part in a range of workshops from theatre companies such as Frantic Assembly, Punchdrunk and Paperbirds and a huge number of theatre trips.
Skills gained
The course develops critical skills including communication, analysis, evaluation, independence of thought and creativity. Time management, the ability to work as a team and leadership skills are developed throughout the course.
University and beyond
The Theatre Studies course is excellent for anyone who is interested in exploring the world of theatre beyond school as a director, actor, producer, designer, and equips you with key skills suitable for careers in areas such as journalism, television, film, media, politics, business, law or communications.
Consider these important questions: Why is it that the NHS is struggling to provide a fully functioning health service? Is it right to compensate the unemployed? Both of which have been at the forefront of the news during the recent labour market problems. Is immigration detrimental to the economy? Is Google too powerful? Why are globalisation and free trade out of favour? How can economics help the overuse of antibiotics and slow the growth of superbugs?
If these questions intrigue you, then the study of Economics will provide you with the critical and analytical tools to begin to answer them. You will be introduced to a number of formal, theoretical models in order to analyse the world. You will be expected to think independently about particular economic issues and discuss your views.
Exam Board: Pearson – Economics A
Why should I study Economics?
The course is designed to introduce new theories to students with no previous experience of studying Economics; however, an appetite for current affairs is essential. The examinations and class discussions are based on the economic phenomena reported every day in the media. The course is challenging as it introduces a new and logical way of looking at the world. It is important to be open-minded and allow yourself to step back from the discussion and evaluate the assumptions it may be resting on.
It should be noted that Business Studies may not be taken alongside Economics as there is too great an overlap in the courses.
What will I study?
Microeconomics, the study of individual markets and the decisions firms and consumers make within them. Topics included are:
• Demand and supply
• Labour markets
• Theory of the firm (monopoly, oligopoly, game theory)
• Market failure and externalities
Macroeconomics, considers the performance of the economy as a whole. Topics studied include:
• Macroeconomic objectives (economic growth, inflation, unemployment, and income inequality)
• Ag gregate demand and aggregate supply
• Globalisation
• Trade blocs and economic integration

• Economic development
Understanding the economy is important both when operating a business and when policymaking in government. However, the intellectual skills developed will be of life-long value:
• Ability to extract and interpret complex data
• Present a coherent argument on paper
• A good grounding in how the national and international economy works
The course is assessed over three papers each of which is two hours long.
Paper 1: Markets and business behaviour assesses the micro content of the course.
Paper 2: The national and global economy assesses the macro content of the course.
Paper 3: Microeconomics and Macroeconomics – this is a synoptic paper drawing on students’ knowledge of all areas of the syllabus.
Students are taken to a variety of lectures and student conferences. They are also encouraged to independently attend lectures at the LSE and supported with essay competition entries held by a number of universities. A weekly extension session is held for those students who wish to explore the subject beyond the confines of the syllabus. Regular support sessions are also offered to help students consolidate their understanding of areas which are of particular concern to them.
Skills gained
The course will enable students to gain a range of transferable skills including:
• Cognitive skills such as non-routine problem solving; decision making and reasoning, critical and ICT literacy
• Interpersonal skills such as communication, relationshipbuilding skills and collaborative problem solving
• Intrapersonal skills such as adaptability, self-management and self-development
Students can progress from this qualification to:
• Higher education courses such as economics degrees with a focus on theory, or degrees in applied economics such as environmental economics, labour economics, public sector economics or monetary economics. Alternatively, students may choose to study a business economics, mathematical economics or business degree
• A wide range of careers ranging from finance, banking, insurance, accountancy, management and consultancy, to becoming professional economists.
If you are considering Economics at university, Mathematics A Level is normally required and certainly Further Mathematics is necessary for Oxbridge and LSE applications.

Reading great books forces us to address important issues. At Bancroft’s we hope to teach not only a detailed understanding of particular texts, exploring ways in which writers shape our views of the world, but also to foster an intellectual and imaginative interest in a wide variety of social and philosophical topics, helping students to read everything with greater insight and more profound pleasure.

Exam Board: Pearson
The study of literature leads us to a greater understanding of ourselves and of those around us; this emotional intelligence enhances performance in any job and, even more importantly, our ability to negotiate a path through the many human issues of living in a family and wider society. The works we study invite us to explore social and philosophical questions which might not otherwise occur to us, and students become increasingly confident in shaping those thoughts into cogent arguments. Discussions during English lessons are thought-provoking and wide in scope. Every class is taught by two teachers in order that a variety of views and approaches may be experienced. The importance of a personal response to the material means that there is room to pursue individual interests.
The course is organised around the principal literary forms
- prose, poetry and drama. The components are:
• Two novels, at least one of which must have been published before 1900
• One Shakespeare play supported by an anthology of extracts from critical essays
• One non-Shakespearean play
• A selec tion of poetry by one writer or from one literary period
• A selec tion of twenty-first century poetry
• Two coursework texts chosen by the set teacher
In the Lower Sixth we study the non-Shakespearean play, two novels linked by theme (e.g. The Supernatural or Women in Society) and approximately half the modern poems. As part of sharpening their essay-writing skills students learn how to analyse and evaluate ways in which writers comment on, and are affected by, their social, historical and cultural contexts. This is enhanced in the study of the novels by the need to compare the texts, promoting understanding of the development of genres and literary themes through time.
The skill of comparing texts is also an important aspect of the coursework unit, which offers an opportunity to develop an extended essay on two related texts, exploring ways in which writers have been influenced by earlier works and literary genres. The process of drafting and redrafting this piece not only improves students’ skills in sharp literary analysis and in developing a cogent argument, but helps them to reach more profound insights into the relationships between literary texts.
In studying the Upper Sixth texts, students will also learn the key academic skill of engaging with critical work in order to inform and develop their own arguments.
This will enable them to enter into intellectual debate at a sophisticated level and help to develop research skills which will be essential in almost any degree course.
The course also features practice in the discipline of Practical Criticism, with students asked to compare an unseen poem to one of the modern poems they have studied. This often leads to some of the most spontaneous examination work for A Level, with students often finding new insights into a poem which they already know in detail.

How will I be assessed?
The course is linear, culminating in three examination papers, with one coursework unit written during the autumn term of the Upper Sixth.
Paper 1 – Drama. One essay on the Shakespeare play, incorporating some of the critical essays; one essay on the non-Shakespearean play.
Paper 2 – Prose. One essay comparing both novels.
Paper 3 – Poetry. One essay comparing an unseen 21st Century poem to one of the prepared poems; one essay on two poems from the other selection studied. Coursework. One essay (c. 3000 words) comparing two texts and incorporating critical material.
How else will my studies be supported?
The work in the classroom is complemented by visits to the theatre, attendance at lectures, and the opportunities to participate in drama and the work of other arts societies within the school. London theatres often stage productions of plays studied or related texts, and there will be trips to relevant exhibitions at museums and galleries. The English Society provides a forum for discussion of works outside the syllabus and hosts contemporary writers. All interested students are welcome to attend Oxbridge preparation classes, and regular revision classes are provided in the second half of the Upper Sixth year.
The ability to organise complex ideas into a coherent argument is one which will be useful in almost any university course and job. The redrafting of coursework sharpens students’ written style and teaches them to adopt a critical and evaluative approach to their own work. As part of the coursework and through the Shakespeare unit, students learn the essential academic discipline of engaging intellectually with the work of other critics, balancing arguments against each other and using them to develop their own thoughts. Analytical and evaluative skills gained through IGCSE English Literature are developed through the A Level course. Classroom discussion helps to develop the verbal skills of articulating complex ideas and assimilating challenging arguments.
An English degree leads very naturally into careers where strong communication skills are essential; for example, journalism, medicine, publishing, advertising, work in media/ the creative industry and public relations. Many English graduates do a Law Conversion course or move into politics or into aspects of the public sector such as government or the civil service. Beyond this, it is impossible to list the range of organisations where the skills listed above will be valued and developed further.

Exam Board:
Cambridge International Education A Level
Why should I study Geography?
Grounded in contemporary 21st Century issues, the geography A Level course investigates a range of global challenges and opportunities for individuals, societies and their environments. Additionally, students gain an integrated understanding of how global economic, developmental and environmental changes have become inter-related over time. During the course, students also acquire a broad range of skills. They learn how to analyse complex data series and how to write in a discursive, well-evidenced and argumentative way. By the end of the course, our students can adopt a multi-disciplinary approach to problem-solving and are independent learners.
Fieldwork has always formed an important and enjoyable part of A Level geography. Students participate in a residential fieldtrip somewhere in the UK; previous destinations have been Devon and South Wales.
What will I study?
Component 1: Core Physical Geography (25%)
• Hydrology and Fluvial Geomorphology
• Atmosphere and Weather
• Rocks and Weathering (Plate Tectonics)
Component 2: Core Human Geography (25%)
• Population
• Migration
• Settlement dynamics (Cities)
Component 3: Advanced Physical Geography (25%)
• Coastal Environments
• Hazardous Environments
Component 4: Advanced Human Geography (25%)
• Environmental Management
• Global Interdependence

How will I be assessed?
This qualification will be assessed through four exams at the end of the two years, each paper being worth 25% as outlined above.
How else will my studies be supported?
The Geography department has subscriptions and access to numerous online resources which can support, challenge and extend your learning. All resources used in the course will be available on Sharepoint and a textbook is also provided. You can become a member of the Royal Geographical Society which enables you to attend their prestigious Monday night lecture program (or watch them online). How will Geography benefit me and what skills will I gain?
Together with this broad curriculum, geography teaches and nurtures a wide range of skills that have enormous relevance and practical application to our everyday lives and range of professions:
• Communication skills, written and spoken
• Numerical, ICT and graphical skills including Geographical Information Systems (GIS)
• Problem-solving and decision-making skills
• Independent research
Geography will provide you with a broad knowledge base and transferable skills that could reward you both academically and advance you professionally. The broad remit of the A Level enables students to engage with a diverse range of topics. These include aspects of earth science, land economy, politics and social anthropology, making geographers strongly employable.
You must have studied GCSE Greek to enable you to follow this course. Please note that you can choose to study AS or A Level Greek, since the material for the AS is covered during the Lower Sixth Year; a decision can be made during the year.
There are two elements to this course: language and literature.

Exam board: OCR
Why should I study Greek?
• You will continue to develop your understanding of the Greek language and the related literature, values and society and, by making comparisons, achieve a better understanding of your own culture.
• You will continue to develop a wide range of transferable skills (e.g. literary criticism, enhanced knowledge of English – including derivations, problem-solving, analysis, historical and textual evaluation, and attention to detail).
• You will read a wide range of interesting and entertaining literature which has influenced the development of European literature and culture.
• You will develop insights into the relevance of Greek and of ancient literature and civilisation to our understanding of our modern world of diverse cultures.
• If you are enjoying Greek so far, you will relish the opportunity to study this fascinating subject in even greater depth.
What will I study?
There are four components:
• Unseen Translation: You will continue to study the Greek language and to widen your vocabulary, beginning with the Defined Vocabulary List. You will read extracts from Xenophon for the Prose Unseen and extracts from Euripides for the Verse Unseen. You will also learn how to scan iambic trimeters.
• Comprehension: You will read a variety of Greek oratory, practising translation and the relevant type of comprehension questions; you will also practise the type of questions which will be asked with regard to accidence and syntax.
• Prose Literature: You will either study selections from Books 7 and 8 of Herodotus’s Histories, in which Herodotus gives his account of the (land) Battle of Thermopylae and the (sea) Battle of Artemisium (the battles took place simultaneously, between the Greeks and the Persians), or selections from Crito by Plato, in which Socrates and Crito discuss the nature of justice and injustice, and the correct response to Socrates’ unjust (in their view) imprisonment. In addition, you will read further selections from the Histories or Crito in English, to enable you to understand the context of your set text more clearly.
• Verse Literature: You will either study selections from Book 16 of Homer’s Odyssey, in which Odysseus and his son Telemachus are reunited after 20 years and plot the downfall of the Suitors, and selections from Book 22, in which they carry out their plan or selections from Sophocles’ Electra, in which Electra and her brother Orestes take their revenge on their mother for killing their father. You will also read the whole of Book 21 and the remainder of Book 22 of the Odyssey or the whole of Sophocles’ Electra in English, to enable you to understand the context of your set text more clearly.
How will I be assessed?
Unseen Translation: this tests AO (Assessment Objective)1 [demonstrate knowledge and understanding of the language] and is worth 100 marks (33% of the total marks for the A Level); it lasts 1 hour 45 minutes. You will translate an unseen passage of Xenophon (50 marks) and an unseen passage of Euripides (45 marks) into English; you will also scan two lines of verse (5 marks).
Comprehension: this tests AO1 and is worth 50 marks (17% of the total marks for the A Level); it lasts 1 hour and 15 minutes. You will answer translation, comprehension and grammar questions on an unseen passage of Greek prose (oratory).
Prose Literature: this tests AO2 [demonstrate knowledge and understanding of literature] and AO3 [critically analyse, evaluate and respond to literature] and is worth 75 marks (25% of the total marks for the A Level); it lasts 2 hours. You will answer questions to show your understanding and appreciation of the set texts (including translation, comprehension and a 15-mark question analysing literary style, characterisation, argument and literary meaning) and write an essay on your set text and the material read in translation.
Verse Literature: this tests AO2 and AO3 and is worth 75 marks (25% of the total marks for the A Level); it lasts 2 hours. You will answer questions to show your understanding and appreciation of the set texts (including translation, comprehension and a 15-mark question analysing literary style, characterisation, argument and literary meaning) and write an essay on your set text and the material read in translation.
How else will my studies be supported?
You may have the opportunity to acquire a deeper understanding of the literature studied and the Classical World in general by attending lectures and conferences on the set texts and a variety of subjects. You will also have the opportunity to attend Classical Society (which holds regular meetings, covering a wide-range of topics) and to research a subject of your choice to enable you to deliver a talk. The opportunity will be available to assist in the running of Junior Classics Club and to enter national essay and/or translation competitions. There may be the opportunity to assist younger pupils who are finding an aspect of the language difficult and to participate in a school visit to either Greece or Italy.
Skills gained
You will continue to develop your ability to understand and translate the Greek language. You will continue to develop precision and logical thinking. You will continue to develop your analytical and evaluative skills.
You will learn to form your own opinions, to select relevant material to support your arguments and to articulate your views coherently.
You will develop an appreciation of the nuances of language and the ability to identify the impact of certain literary aspects on the reader.
You will develop your clarity of thought and expression, writing with increased sophistication as a result of your enhanced linguistic awareness and appreciation of style.
University and beyond
Greek may be studied further as part of a highly-regarded Honours course in Classics or as part of a Joint Honours course. The intellectual qualities which will be developed by a Classics graduate are in great demand in a wide range of careers; employers especially value the diverse skillset which Classics graduates have built up during their studies. Those who continue to study Greek at university often proceed to careers in journalism, politics, the legal profession, industry, commerce, banking, accountancy or the computing world.
Exam Board: OCR
A Level History challenges students’ minds and will help them to develop clear, concise and accurate powers of expression, orally and on paper. Students who wish to read widely, learn to research independently, like questioning and arguing, both in small groups and as a class, will find much to enjoy in our study of the past. A good GCSE pass in History is desirable as a foundation for the skills required at A Level but is not a requirement; only an open mind and enthusiasm!
The Department is proud of its longstanding tradition of teaching a broad range of different historical periods and helping students interpret the past of a wide variety of peoples and nations. Each student will study four units and at least 200 years of history. They will consider the changing relationship between rulers and their subjects, why wars are fought and how are they won, why nations and empires unite and divide, how economics shape past societies and how competing religions and ideologies have developed and how they have come into conflict.
The department delivers two distinct periods of history, Early Modern and Modern. Each course is made up of complementary units designed to deepen your understanding of the periods being studied. Students can choose which of the two periods they would prefer and the school will accommodate your choice as far as is possible. Please remember that the issues which we address are remarkably similar in both periods and that you should opt for History due to general enthusiasm to explore past human experiences rather than any particular period.

In the Early Modern course you will learn about -
• ‘The Crusades 1095 – 1193’ – a violent pilgrimage by Western European kings, knights, monks and priests into the heart of the Middle East to reclaim Jerusalem from Islam.
• ‘The Early & Mid Tudors 1485 – 1558’ – political and economic turmoil as Henry VII attempts to establish the Tudor dynasty on England’s throne before his son and grandchildren unleash war, rebellion and religious division with the English Reformation.
• ‘The Catholic Reformation 1492 – 1610’ – the Catholic Church fights back globally, from Germany to Japan, against the rise of Protestantism and other faiths.
• The Independent Study – a coursework element tackled in the Upper Sixth in which students pursue their own historical interests and, through independent research, discover the answer to a question which they have researched. Recent topics have included the reign of Queen Elizabeth, the Ottoman Empire, Charlemagne and Witchcraft persecutions.
In the Modern course you will learn about -
• ‘Germany 1789 – 1919’ – the ideas, revolutions, wars and leaders that united Germany into a single state before ultimately leading the nation to disaster in the Great War.
• ‘Russia 1894 – 1941’ – from the collapse of the hated Russian monarchy amid war and revolution to the rise of Lenin, Stalin and the waves of terror they unleashed on Russian society.
• ‘Britain 1930 – 1997’ – the career of Winston Churchill and his role in the Second World War followed by Britain’s post war economic decline and the end of the British Empire.
• The Independent Study – A coursework element tackled in the Upper Sixth in which students pursue their own historical interests and, through independent research, discover the answer to a question which they have researched. Recent topics have included the careers of Gladstone & Disraeli and the expansion of the British Empire in the Victorian period.

The course will be assessed through three formal examinations (80%) and coursework (20%). Much like GCSE History, the examinations will test the pupil’s ability to construct convincing arguments using detailed evidence to explain and judge historical events. Students will also be expected to analyse and evaluate historical evidence for meaning and accuracy and weigh the interpretations of other historians.
Regular history trips are organised to support your studies; some are local visits to sites such as the Cabinet War Rooms or Westminster Abbey in London while others are further afield to Moscow, St Petersburg, Rome or Paris. The Department also regularly organises access to lectures delivered by top historians both inside and outside school. To extend knowledge beyond the syllabus, a pupil researched and written termly history magazine, Past Paper, is published and a successful preparation programme is offered to those planning on pursuing history at university.
Through discussion and reading students will develop an in-depth understanding of the period, societies and cultures they study. Critical thinking and evaluation skills will be nurtured allowing pupils to identify truth and recognise myth, propaganda and downright lies both in a historical context and in the world around them. Confidence and communication skills will also be fostered, allowing pupils to communicate an argument effectively on paper and in oral debate. Through their studies of the past, they will learn about people, how they interact, what motivates them to work together in common cause or tears them apart into rivalries. They will also gain a broader insight into modern international relations and gain a better understanding of government institutions, ideologies both political and religious, social divisions and economics.
A Level History may lead to a degree in History, Ancient and Modern History, Archaeology or Law but would also contribute as an A Level to any student hoping to study any of the Humanities, an ancient or modern foreign language, or a Social Science at degree level. No career path is closed by the study of History at A Level and our past students have gone on to pursue careers in medicine, consulting, the media, marketing, management, law, teaching, research, finance, publishing, conservation, tourism, the Civil Service and the Armed Forces.
You must have studied GCSE Latin to enable you to follow this course. Please note that you can choose to study AS or A Level Latin, since the material for the AS is covered during the Lower Sixth Year; a decision can be made during the year. There are two elements to this course: language and literature.
Exam board: OCR
Why should I study Latin?
• You will continue to develop your understanding of the Latin language and the related literature, values and society and, by making comparisons, achieve a better understanding of your own culture.
• You will continue to develop a wide range of transferable skills (e.g. literary criticism, enhanced knowledge of English –including derivations, problem-solving, analysis, historical and textual evaluation, and attention to detail).
• You will read a wide range of interesting and entertaining literature which has influenced the development of European literature and culture.
• You will develop insights into the relevance of Latin and of ancient literature and civilisation to our understanding of our modern world of diverse cultures.
• If you are enjoying Latin so far, you will relish the opportunity to study this fascinating subject in even greater depth.
What will I study?
There are four components:
• Unseen Translation: You will continue to study the Latin language and to widen your vocabulary, beginning with the Defined Vocabulary List. You will read extracts from Livy for the Prose Unseen and extracts from Ovid for the Verse Unseen. You will also learn how to scan hexameters and elegiac couplets.
• Comprehension: You will read a variety of Latin texts, practising translation and the relevant type of comprehension questions; you will also practise the type of questions which will be asked with regard to accidence and syntax.
• Prose Literature: You will study selections from Cicero’s pro Roscio Amerino, in which Cicero eloquently defends Sextus Roscius from Ameria (a city in Central Italy) who is accused of murdering his own father; Cicero finds vigorous methods to defend him, and adopts the tactic of naming those whom he thinks are actually guilty of the murder. You will also study selections from Book XIV of Tacitus’s Annals, in which Tacitus describes the revolt of Boudicca against the Romans and various antics of the Emperor Nero. In addition, you will read further selections from the Annals in English, to enable you to understand the context of your set text more clearly.
• Verse Literature: You will study selections from Book 4 of Virgil’s Aeneid, in which Dido, the Queen of Carthage, and Aeneas embark on a relationship (despite Aeneas’ mission to sail to Italy to found the city which will become Rome) until Mercury tells Aeneas to set sail; this has devastating consequences for Dido. In addition, you will read the whole of Book 4 and selections from Book 1 of the Aeneid in English, to enable you to understand the context of your set text more clearly.
Unseen Translation: this tests AO (Assessment Objective)1 [demonstrate knowledge and understanding of the language] and is worth 100 marks (33% of the total marks for the A Level); it lasts 1 hour 45 minutes. You will translate an unseen passage of the Latin prose author Livy (50 marks) and an unseen passage of Ovid’s Latin verse (45 marks) into English; you will also scan two lines of verse (5 marks) – either two hexameters or an elegiac couplet (a hexameter and a pentameter).
Comprehension: this tests AO1 and is worth 50 marks (17% of the total marks for the A Level); it lasts 1 hour and 15 minutes. You will answer translation, comprehension and grammar questions on an unseen passage of Latin prose.
Prose Literature: this tests AO2 [demonstrate knowledge and understanding of literature] and AO3 [critically analyse, evaluate and respond to literature] and is worth 75 marks (25% of the total marks for the A Level); it lasts 2 hours. You will answer questions to show your understanding and appreciation of the set texts (including translation, comprehension and a 15mark question analysing literary style, characterisation, argument and literary meaning) and write an essay on the Tacitus set text and the material read in translation.
Verse Literature: this tests AO2 and AO3 and is worth 75 marks (25% of the total marks for the A Level); it lasts 2 hours. You will answer questions to show your understanding and appreciation of the set texts (including translation, comprehension and a 15-mark question analysing literary style, characterisation, argument and literary meaning) and write an essay on the Virgil set text and the material read in translation.
How else will my studies be supported?
You may have the opportunity to acquire a deeper understanding of the literature studied, and the Classical World in general, by attending lectures and conferences on the set texts and a variety of subjects. You will also have the opportunity to attend Classical Society (which holds regular meetings, covering a wide-range of topics) and to research a subject of your choice to enable you to deliver a talk. The opportunity will be available to assist in the running of Junior Classics Club and to enter national essay and/or translation competitions. There may be the opportunity to assist younger pupils who are finding an aspect of the language difficult and to participate in a school visit to either Greece or Italy.
Skills gained:
You will continue to develop your ability to understand and translate the Latin language.
You will continue to develop precision and logical thinking.
You will continue to develop your analytical and evaluative skills.
You will learn to form your own opinions, to select relevant material to support your arguments and to articulate your views coherently.
You will develop an appreciation of the nuances of language and the ability to identify the impact of certain literary aspects on the reader.
You will develop your clarity of thought and expression, writing with increased sophistication as a result of your enhanced linguistic awareness and appreciation of style.
University and beyond:
Latin may be studied further as part of a highly-regarded Honours course in Classics or as part of a Joint Honours course. The intellectual qualities which will be developed by a Classics graduate are in great demand in a wide range of careers; employers especially value the diverse skillset which Classics graduates have built up in the course of their studies. Those who continue to study Latin at university often proceed to careers in journalism, politics, the legal profession, industry, commerce, banking, accountancy or the computing world.
Mathematics is the study of abstract patterns and problem solving. It is the development of another language in which we communicate concepts, situations and ideas. It is this ‘abstract’ nature that means that its methods and results are applicable in almost all aspects of our physical world.
Exam Board: Pearson
Why should I study Mathematics and Further Mathematics?
Mathematics is the language of the scientific world and heavily supports many other subjects. It is one of the most desired subjects for the widest range of University courses and employers; mathematicians are problem solvers, logicians, numerically astute and accurate, making them eminently employable in a wide range of fields.
What will I study?
Single Mathematics
All students will follow the same two-year A Level Mathematics course, and the public examinations will take place at the end of the two-year course.
• Pure Mathematics:
This comprises of two thirds of the total content of the course. It focuses on such topics as algebra, calculus, trigonometry, vectors and proof.
• Statistics:
This comprises one sixth of the course . This is the application of Pure Mathematics to matters of uncertainty, probability and data and its representation. In particular, the course covers the binomial and normal distributions, conditional probability, correlation and hypothesis testing.
• Mechanics:
This comprises one sixth of the course . This deals with the way we can use equations to solve problems relating to physical objects and their motion and interaction. In particular, we study Newton’s laws, friction, moment forces, projectiles and constant or variable acceleration in one or two dimensions.
Further Mathematics consists of two distinct A Levels: A Level Mathematics (the same course as Single Mathematics) and A Level Further Mathematics. Both A Levels will be sat at the end of the Upper Sixth, but they are studied successively with Mathematics studied in the Lower Sixth and Further Mathematics studied in the Upper Sixth. The Further Mathematics course consists of 4 modules:
• Pure Mathematics:
The modules Fur ther Core Pure 1 and Further Core Pure 2 each make up 25% of the course. Topics studied will include differential equations, further vectors, hyperbolics, complex numbers, polar geometry, power series and proof by induction.
• Further Applied Mathematics:
The modules Fur ther Mechanics 1 and Further Statistics 1 each make up 25% of the course. The mechanics element contains topics such as collisions, work and energy, elasticity, dynamics and kinematics. The statistics element contains topics such as random variables, the geometric and negative binomial distributions, chi-squared distributions and tests, the central limit theorem and probability generating functions.
The majority of students who elect to study Further Mathematics have completed the FSMQ Additional Mathematics. Whilst this is extremely advantageous, it is not absolutely necessary and students can self-study material over the summer to catch up.
This is not a task to be taken lightly; students in this position should have a discussion with the Head of Mathematics before the summer break following their GCSE exams.
If a student has taken Further Mathematics in the Lower Sixth and feels that A Level Further Mathematics will be too challenging for them in the Upper Sixth, it may be possibly to elect to study AS Further Mathematics. Similarly, if a student has opted for Single Mathematics and would like to supplement their studies in the Upper Sixth then it may be possible to opt for AS Further Mathematics.
The Advanced Extension Award is for many students the first steps towards preparing for a scientific or mathematical course at Oxbridge and provides the opportunity to dig deeper into the mathematical curriculum by solving more difficult problems in teams. There is no additional content presented; the course focuses on problem solving techniques and different ways of thinking about Mathematics.
How will I be assessed?
Single Mathematics consists of three exams; two on the pure syllabus and one combined mechanics and statistics paper. All papers carry equal weight. Further Mathematics students will sit the same three exams as single Mathematics students, plus four Further Mathematics papers.
How else will my studies be supported?
Many extension classes from the AEA course to STEP preparation and interview practice are offered. Support classes are tailored to students and offered where necessary. Students are given the opportunity to attend lectures and masterclasses alongside taking part in various UKMT events and other competitions such as codebreaking and the inter-school Hans Woyda competitions.
Skills gained
• Problem solving
• Logical reasoning
• The ability to present an argument using precise technical language
• The ability to check work and achieve accuracy
University and beyond
If you are thinking about studying a Science, Engineering or Economics degree at university, you will almost certainly find that you will be glad you studied A Level Mathematics; students are also advised to consult with university department websites to determine whether Double or Single Mathematics is considered to be essential or preferred for their chosen course of study. Further Mathematics is usually required for Engineering, Computing, Physics or Economics at Oxford, Cambridge, LSE and Imperial College.



The aims are to develop the skills of communication associated with GCSE, and to broaden an interest in aspects of the French, German, and Spanish-speaking worlds in an enjoyable and stimulating way. These courses will appeal to those who wish to broaden their intellectual horizons and awareness of contemporary issues. It is not possible to do these subjects without having done them at GCSE. Please note that you can choose to study AS or A Level French, German or Spanish-the courses are taught parallel and you can take a decision later in the year.
Exam Board: AQA
Why should I study Modern Languages?
• To use the language for practical communication
• To develop a better understanding of other cultures
• To build a bank of transferable skills which will be useful in your other subjects, future studies and work
What will I study?
• Aspec ts of French/German/Spanish-speaking society: current trends and issues
• Ar tistic culture in the French/German/Spanish-speaking world
• Aspects of political life (A Level only)
• Grammar
• One literary text/ one film
How will I be assessed?
AS Level

Paper 1: Listening, reading and writing 1 hour 45 minutes
90 marks - 45% of AS Level
• Lis tening, reading and responding to spoken and written passages from a range of contexts and sources covering different registers and adapted as necessary. (80 marks)
• Translation into English; a passage of 70 words (10 marks)
Paper 2: Writing 1 hour 30 minutes
50 marks - 25% of AS Level
• Translation into French/German/Spanish; a passage of minimum 70 words (15 marks).
• Either one ques tion in French/ German/Spanish on a set text from a choice of two questions or one question on a set film from a choice of two questions (35 marks).
Paper 3: Speaking 12–14 minutes (plus 15 minutes preparation time)
60 marks - 30% of AS Level
• Discussion of two sub-themes (6–7 minutes on each) with the discussion based on a stimulus card for each sub-theme.
Paper 1: Listening, reading and writing
2 hours 30 minutes
100 marks - 50% of A Level
• Lis tening and responding to spoken passages from a range of contexts and sources covering different registers and adapted as necessary. (30 marks).
• Reading and responding to a variety of texts written for different purposes, drawn from a range of authentic sources and adapted as necessary. (50 marks).
• Translation into English; a passage of minimum 100 words (10 marks).
• Translation into French/German/Spanish; a passage of minimum 100 words (10 marks).
Paper 2: Writing
2 hours
80 marks – 20% of A Level
• Either one ques tion on a set text from a choice of two questions, or one question on a set film from a choice of two questions, alternatively two questions on set texts from a choice of two questions on each text.
Paper 3: Speaking
21-23 minutes (incl. 5 minutes preparation time)
60 marks – 30% of A Level
• Discussion of a sub-theme with the discussion based on a s timulus card (5 –6 minutes). (25 marks).
• Presentation (2 minutes) and discussion (9 –10 minutes) of Individual Research Project (35 marks).
How else will my studies be supported?
In addition to normal lessons, A Level language students attend weekly conversations lessons with a native speaker who helps them to build confidence in the spoken language and to prepare for the speaking exam. Students will be expected to take part in residential visits abroad, outings to foreign theatre productions in London, and wider reading, all of which are strongly encouraged and facilitated by the department.
Skills gained
• Communication
• Open-mindedness
• Resilience
• Logical thinking
• Attention to detail
• Ability to analyse films and literature critically University and beyond
An A Level in a Modern Foreign Language is the perfect basis for further study in languages or linguistics. The skills learnt will enhance your university applications for any literary based degree, film studies, social and political sciences, history, geography and philosophy. A language will make your application for medicine, mathematics or sciences betterrounded and can provide you with a competitive edge in international business.

There is much music making at Bancroft’s School with a huge variety of settings and repertoire. For those students who wish to explore music in a more analytical context the A Level course provides students the opportunity to do this in a complimentary way to the Co-curricular programme.
Exam Board: Eduqas
Why should I study Music?
The study of music gives us insight to composer’s thoughts in the act of composition, and helps us to understand, through the use and exploration of musical elements, what a composer’s intentions were at the outset. It also gives us an awareness of the elements that are used in music to create emotion and effect. Music lessons are taught by a variety of teachers who guide you through different components of the course.
What will I study?
AS Level
Component 1: Performing accounts for 30% and is assessed by a visiting examiner in a live recital. Component 2: Composing accounts for 30% and is externally assessed by the exam board.
Component 3: Appraising accounts for 40%. It is a written exam lasting 1 hour and 30 minutes and is divided into two parts:
1. Area of Study A: The Western Classical Tradition –this is a compulsory area of study and focuses on the development of the symphony from 1750 – 1830. You will choose 1 set work from a choice of two for detailed analysis.
2. Area of Study B, C, or D – With the guidance of your teacher, you will choose one area from – Rock and Pop, Musical Theatre, and Jazz.
Components 1: Performing and Component 2:
Composing add up to a total of 60% of your final A Level grade, but you can choose whether you would like to do more performing or more composing.
If you choose Option A:
• Performing will be worth 35% - and your performances will last a total of 10 – 12 minutes.
• Composing will be worth 25% - and your compositions will last a total of 4 – 6 minutes. If you choose Option B:
• Performing will be worth 25% - and your performances will last a total of 6 – 8 minutes.
• Composing will be worth 35% - and your compositions will last a total of 8 – 10 minutes. You are encouraged to choose the option that play to your strengths as a musician and your teacher will guide you in this respect.
Component 3: Appraising accounts for 40% of the A Level and is assessed in a written exam lasting two hours and 15 minutes. It is divided into three parts:
1. Area of Study A: The Western Classical Tradition –this is a compulsory area of study and focuses on the Development of the Symphony from 1750 – 1830. You will choose one set work from a choice of two for detailed analysis.
2. Area of Study B, C, or D – You will choose one area from – Rock and Pop, Musical Theatre, and Jazz.
3. Area of Study E or F – You will choose only one of these areas of study, they are based on periods of musical history: Into the Twentieth Century, and Into the Twenty-first Century. Each area of study includes two set works.

How else will my studies be supported?
There will be opportunities to attend live performances of the set works. Music department staff are always on hand to support and answer questions or clarify when new concepts are challenging. The music department also has many scores available for you to borrow to extend your listening and practice your score reading. Alongside this you will be supported in performance and composition through a range of workshops and masterclasses.
Skills gained
Music inspires creativity and expression and, in many ways can complement and enhance other A Level choices. You will gain skills in analysing scores to a high level, applying musical knowledge and understanding in a way that you may not have experienced before. You will increase your confidence as a performer and composer, and learn to develop your own ideas and consider constructive feedback.
University and beyond
You may want to study music at University or at Conservatoire level depending on your specialism and instrument. A music degree can lead to employment in the music industry or as a performer, producer, composer or teacher. It is considered a rigorous degree with a number of transferable skills; many graduate programmes welcome applicants from the field of music.

A context-based course across a broad range of Physics principles including mechanics, waves and electricity.
Exam Board: Pearson
Why should I study Physics?
If you are interested in ‘how things work’ across a scale from atoms to galaxies, then this is the course for you. Physics develops skills that are highly prized by employers, such as mathematical ability, analytical thinking, communication of ideas and practical aptitude, making it one of the best vocational subjects to study. Finance and Engineering are the two largest employment sectors for physicists.
What will I study?
The course is split over the two years into 11 contextbased chapters, covering the Physics involved in Sport, Space Technology, Music, Food production, Medicine, Archaeology, The Eurostar, Media, Particle Physics, Earthquakes & Architecture, Stars & The Universe.
How will I be assessed?
Academic and practical skills are both assessed, leading to an exam-based grade and a separate practical endorsement certificate. There are 3 terminal exam papers, of which 40% of the content will test mathematical ability. Across the 2 years of study, there is a suite of 16 required practicals that will be used to assess experimental and communication skills.
How else will my studies be supported?
There is an extensive programme of support throughout the 2 years, both in and out of the classroom. Extension initiatives, such as ‘PhySoc’ and Isaac Physics, are designed to push those considering Physics/Engineering at university beyond the classroom requirements. Support clinics also run weekly, for those needing further explanation and assistance. Various trips/events are held throughout the course, including regular Cambridge, UCL & Royal Institution lectures, Diamond Synchrotron, Greenwich Royal Observatory, JET fusion reactor. Pupils are encouraged to obtain ‘Insight into University’ engineering placements at select universities and to enter Oxbridge essay competitions.
Skills gained
Primary skills developed throughout the course include Mathematical techniques, Data handling, IT skills, Experimental skills, Communication, Independence, Creativity and Innovative thinking.
University and Beyond
We have a very successful Physics/NatSci/Engineering application history to various top institutions, reflecting the broad range of skills demonstrated by many of our pupils and their correspondingly strong academic performances.

As this subject is not offered at GCSE, it is open at A Level to anyone with a lively interest in the current political scene!

Exam Board: Pearson
Why should I study Politics?
Primarily because in the era of Brexit and Trump, not to mention a global pandemic and its ongoing ramifications, it is more relevant than ever. We aim to help students gain a critical awareness of the nature of contemporary politics, alongside an introduction to broader political theory, and to help them form opinions based on fact and logical thinking.
The syllabus involves the study of a variety of issues central to contemporary British and American politics, as well as an introduction to political theory via four ideologies.
UK Politics:
British Politics introduces the student to the study, through examination of the representative process in the UK, of the key principles in British politics: citizenship, democracy and political participation. We will study political parties, how elections work around the UK and why voters make the choices they do.
British Government provides an introduction to the major institutions of the UK Government and examines their relationships with one another, especially the House of Commons, the Prime Minister and Cabinet as well as the Judiciary. We will also consider their effectiveness within the context of the Brexit process and other contemporary concerns such as the cost of living crisis.
American Politics:
The course looks at the representative processes of the US political system and considers their adequacy in terms of popular participation and full democracy. Areas of study focus on Elections and Voting, Political Parties, Pressure Groups and Racial / Ethnic issues. It also examines the institutional framework of US government and considers the interrelationships between its legislative, executive and judicial processes and the health of US federalism. Areas of study focus on the Constitution, Congress, Presidency and the Supreme Court. Comparisons are made between all areas of UK and US politics.
Political Theory:
Students will study the theory and practice behind the key ideologies of conservatism, liberalism and socialism, along with another ‘ism’ with great contemporary relevance, nationalism.
How will I be assessed?
Politics is an entirely essay-based subject, including some source analysis. Three papers will be sat at the end of the Upper Sixth.
How else will my studies be supported?
No prior knowledge is needed, just a desire to explore new ideas with an open mind, a willingness to read a broad-sheet newspaper or news magazine on a regular basis and follow current affairs on radio, television and in cyberspace (podcasts are great for this!). You should enjoy argument and debate, listening to others as well as voicing your own opinions.
During the course of the Spring term in the Lower Sixth students have the opportunity to visit the Palace of Westminster. This is an excellent opportunity to have a guided tour of Parliament and to place academic studies into context. In the Autumn term of the Upper Sixth students usually take part in a conference in London focused on contemporary American issues. Bancroftians regularly take part in Model United Nations conferences, and these can be particularly relevant to Politics students.
Skills gained
Students have the opportunity to:
• Develop powers of critical thinking in order to communicate and argue effectively on paper and in oral discussions.
• Unders tand and form opinions on the major political issues facing the UK and other major democracies (whilst still retaining an open mind), enhancing their role as informed citizens and voters.
• Develop an understanding of political theories - and their limitations!
University and beyond
Taking Politics A Level might lead on to pursuing a degree in Politics or International Relations, but it would also contribute (in combination with facilitating subjects) to pursuing a degree in any of the Humanities or Social Sciences. It will certainly provide a broader understanding of the many complex issues facing those engaged in the political process, hopefully encouraging those who have studied it to become more active participants in the political sphere.


A Level Psychology offers a unique insight into human behaviour and mental processes. The course delves into various psychological theories and experiments, fostering a deeper understanding of topics such as social influence, attachment, mental disorders and biopsychology. A Level Psychology not only enhances academic knowledge but also provides practical applications in everyday life and future careers in fields such as healthcare, education, and business. By exploring the complexities of the mind, you will develop a scientific approach to problemsolving, making it a valuable and enriching subject choice.

Exam Board: AQA
Why should I study Psychology?
• To develop critical thinking skills
• To better understand the world you live in
• To gain an insight into the reasons why people behave the way they do.
What will I study?
Paper one
• Introductory topics in psychology:
• Social influence
• Attachment
• Memory
• Psychopathology
Paper two
• Psychology in context:
• Approaches in psychology
• Biopsychology
• Research methods
Paper 3
• Issues and options in psychology:
• Issues and debates
• Relationships
• Aggression
• Schizophrenia
How will I be assessed?
The course is assessed over three Papers each of which is two hours long. There are 96 marks available in each paper. All papers are weighted equally. You will be assessed on your ability to describe knowledge (A01), apply your knowledge to novel scenarios (A02) and evaluate theories and studies (A03).
How else will my studies be supported?
Your learning will be supplemented by a number of online platforms which offer tailored support to your needs. There will also be opportunities to attend lectures given by esteemed psychologists from a broad range of fields for example cognitive and developmental psychology. In addition, the department will run regular support sessions in order to help students consolidate any areas of difficulty.
Skills gained Studying A Level psychology will equip you with a deep understanding of human behaviour and mental processes. You will gain critical thinking and analytical skills by evaluating theories and research methods. Through studying various psychological approaches, you will develop strong problem-solving abilities and learn to design and conduct experiments. You will also enhance your communication skills by articulating complex concepts and findings clearly. Additionally, this course fosters empathy and cultural awareness, as you explore diverse perspectives on behaviour and mental health. Overall, A Level psychology provides a solid foundation for further education and various career paths in psychology and beyond.
University and beyond
A Level psychology covers key theories, studies, and approaches within the field, providing a solid foundation in understanding human behaviour, cognition, and emotion. You will learn about research methodologies, experimental design, data collection, and statistical analysis, which are crucial for conducting scientific research at university level. A psychology degree opens doors to diverse careers. Graduates can work as clinical or counselling psychologists, school psychologists, or researchers. They are also suited for roles in human resources and marketing. Additional opportunities include social services, forensic psychology, sports psychology, and neuropsychology with further specialisation.

A Level Religious Studies explores the existence of God, morality and Christian Theology at a deep level. These questions require an understanding of three disciplines - Philosophy of Religion, Ethics and Theology. Studying RS at GCSE is preferable but not required.
Exam board: OCR
Why should I study Religious Studies?
Religious Studies at A Level will suit pupils who are openminded and willing to look at the world in whole new ways. If you want to challenge your preconceptions, engage with the world’s most prominent thinkers, and build your ability to argue, this may be the subject for you.
What will I study?
The course is comprised of three separate strands: Philosophy
This strand considers fundamental questions of existence and reality with an exploration of works of Plato and Aristotle. The course also considers a range of philosophical arguments for the existence or nonexistence of God, introducing students to a range of theologians and philosophers including Thomas Aquinas, David Hume and Bertrand Russell. Finally, this strand questions the nature of philosophical and religious language, including the ideas of 20th Century philosophers such as AJ Ayer and Ludwig Wittgenstein. Ethics
This topic explores questions of morality and whether right or wrong acts are fixed or changing, depending on the situations and outcomes. Students will encounter the absolute ethical ideas of Immanuel Kant, as well as the consequentialist approach adopted by the utilitarian thinkers Jeremy Bentham and JS Mill. The nature and role of conscience in moral decision-making also features in this component of the course, as well as how moral theories can be applied to the issues of euthanasia and of business ethics.
Developments in Christian Thought
Pupils are introduced to a wide range of theological concepts, including an examination of pluralism within society and whether or not there is a life after death. The role of religion in morality is explored through analysis of the life and ideas of Dietrich Bonhoeffer, the Christian pastor who was famously associated with a plot to assassinate Adolf Hitler. Along with this, pupils consider the fundamental ideas facing religion today including the idea of gender in theology and the increasing secularisation of society.

How will I be assessed?
There are three, 2 hour examinations at the end of the course, in Philosophy of Religion, Ethics and Developments in Christian Thought.
How else will my studies be supported?
Visiting speakers have historically been invited into school, and trips to conferences and presentations have also supported pupil studies. We also have an extensive collection of further reading and audio/video online content, as well as possibilities for entering university-run essay competitions, to develop written and thinking skills further.
Skills gained
The course intends to develop and encourage specific skills of critical analysis. As a consequence, you will develop the ability to argue coherently and effectively, both through your verbal contributions in lessons and through your written work. This will develop your ability to elucidate your ideas and use logic and reasoning to defend positions.
and beyond
The critical thinking skills that you will gain in RS will be useful across a variety of different subjects at university, irrespective of whether they are humanities or scientific, since they are valuable for developing intelligent, interesting and effective arguments. Many employers are looking for candidates who are articulate and analytical, and these are both skills developed throughout the course of the RS A Level. A degree in Philosophy or Theology or other related disciplines, including Anthropology and Psychology, can be a useful starting point for a career in law, the City, the Civil Service, academia and teaching, and many others.
Over the course of the Lower Sixth year, students will learn how to conduct an extended piece of research, then develop it into a project of their choosing. The aim is for students to learn independent working, project management, critical thinking and analytical skills, while applying them to a topic of their interest.
Exam Board: Pearson
Why should I do an EPQ?
The EPQ presents a unique opportunity for you to choose a subject of study, then develop a project to suit those interests. There is a focus on research and presentation skills, which you will get to use while you work. This is good preparation for university and professional work, when independent working and the ability to develop a plan and manage its completion will be essential. Many students have found that universities will make a reduced offer when that student has a good EPQ grade.
What will I study?
All Lower Sixth pupils will learn research skills, such as planning, locating and obtaining resources, referencing, constructing and evaluating arguments, along with presentation skills. Pupils doing an EPQ will then propose a research question that fits into one of the following streams:
• Dissertation – A piece of writing that explores a question that analyses information you have gathered about your topic of choice
• Investigation – A scientific experiment or field study that takes place over a longer period of time, which you will then analyse at length
• Performance – A performative work that explores a particular topic, with a description of the process by which you developed it
• Artefact – A piece of physical work that fulfils a design brief, along with a description of how you have come to make it
With guidance from your teacher, you will develop your ideas and create a project that achieves the goals you set at the beginning of the process.
The completed project will be assessed, but it is the process of creating it that really matters. You are judged on:
• How well you manage the project
• Your appropriate use of resources
• Your analysis of the resources and ideas
• Your final review of the process
In the final stage, you will complete a short presentation on your findings and overall review of the project. Your teacher will assess your project, which is then standardised by the EPQ team to ensure fairness.
How else will my studies be supported?
There are no special skills required at the outset of the project. We will teach you all you need to learn and guide you through the process. Each project is dealt with on its own terms, and will receive individual attention, tailored to the student carrying it out. As a result, you will get the support needed to gain skills and to complete your project successfully.
An EPQ will teach you to plan a project, locate and obtain appropriate resources, reference properly, construct and evaluate arguments, make a presentation and think critically.
University and beyond
Universities understand the value of work on an EPQ for students as they make the transition to more open and independent styles of learning. There are many that will make a reduced offer based on the successful completion of such a project, and it is certainly useful to be able to discuss such in-depth study in a personal statement or interview situation. More importantly, the universities will all recognise the utility of the skills acquired during the completion of an EPQ.
Young people today are entering a workplace where new technologies are changing the way in which business is done. As a result, ability to access important information and synthesise it into a working knowledge is becoming more important than ever. The EPQ can help train you to do this in a safe setting with someone to guide you along the way.

Tuesday 24 September 2024 Open Evening
Monday 30 September
Friday 11 October
Friday 01 November
Closing date for completion of IAIF* for Assisted Places
Closing date for registrations
Extrance exams at Bancroft’s School
Saturday 16 November Interviews (by invitation)
Monday 02 December
Friday 06 December
Monday 06 January 2025
*Initial Assessment of Income Form
Offers emailed
Offer Holder Morning
Acceptance deadline: 10am










